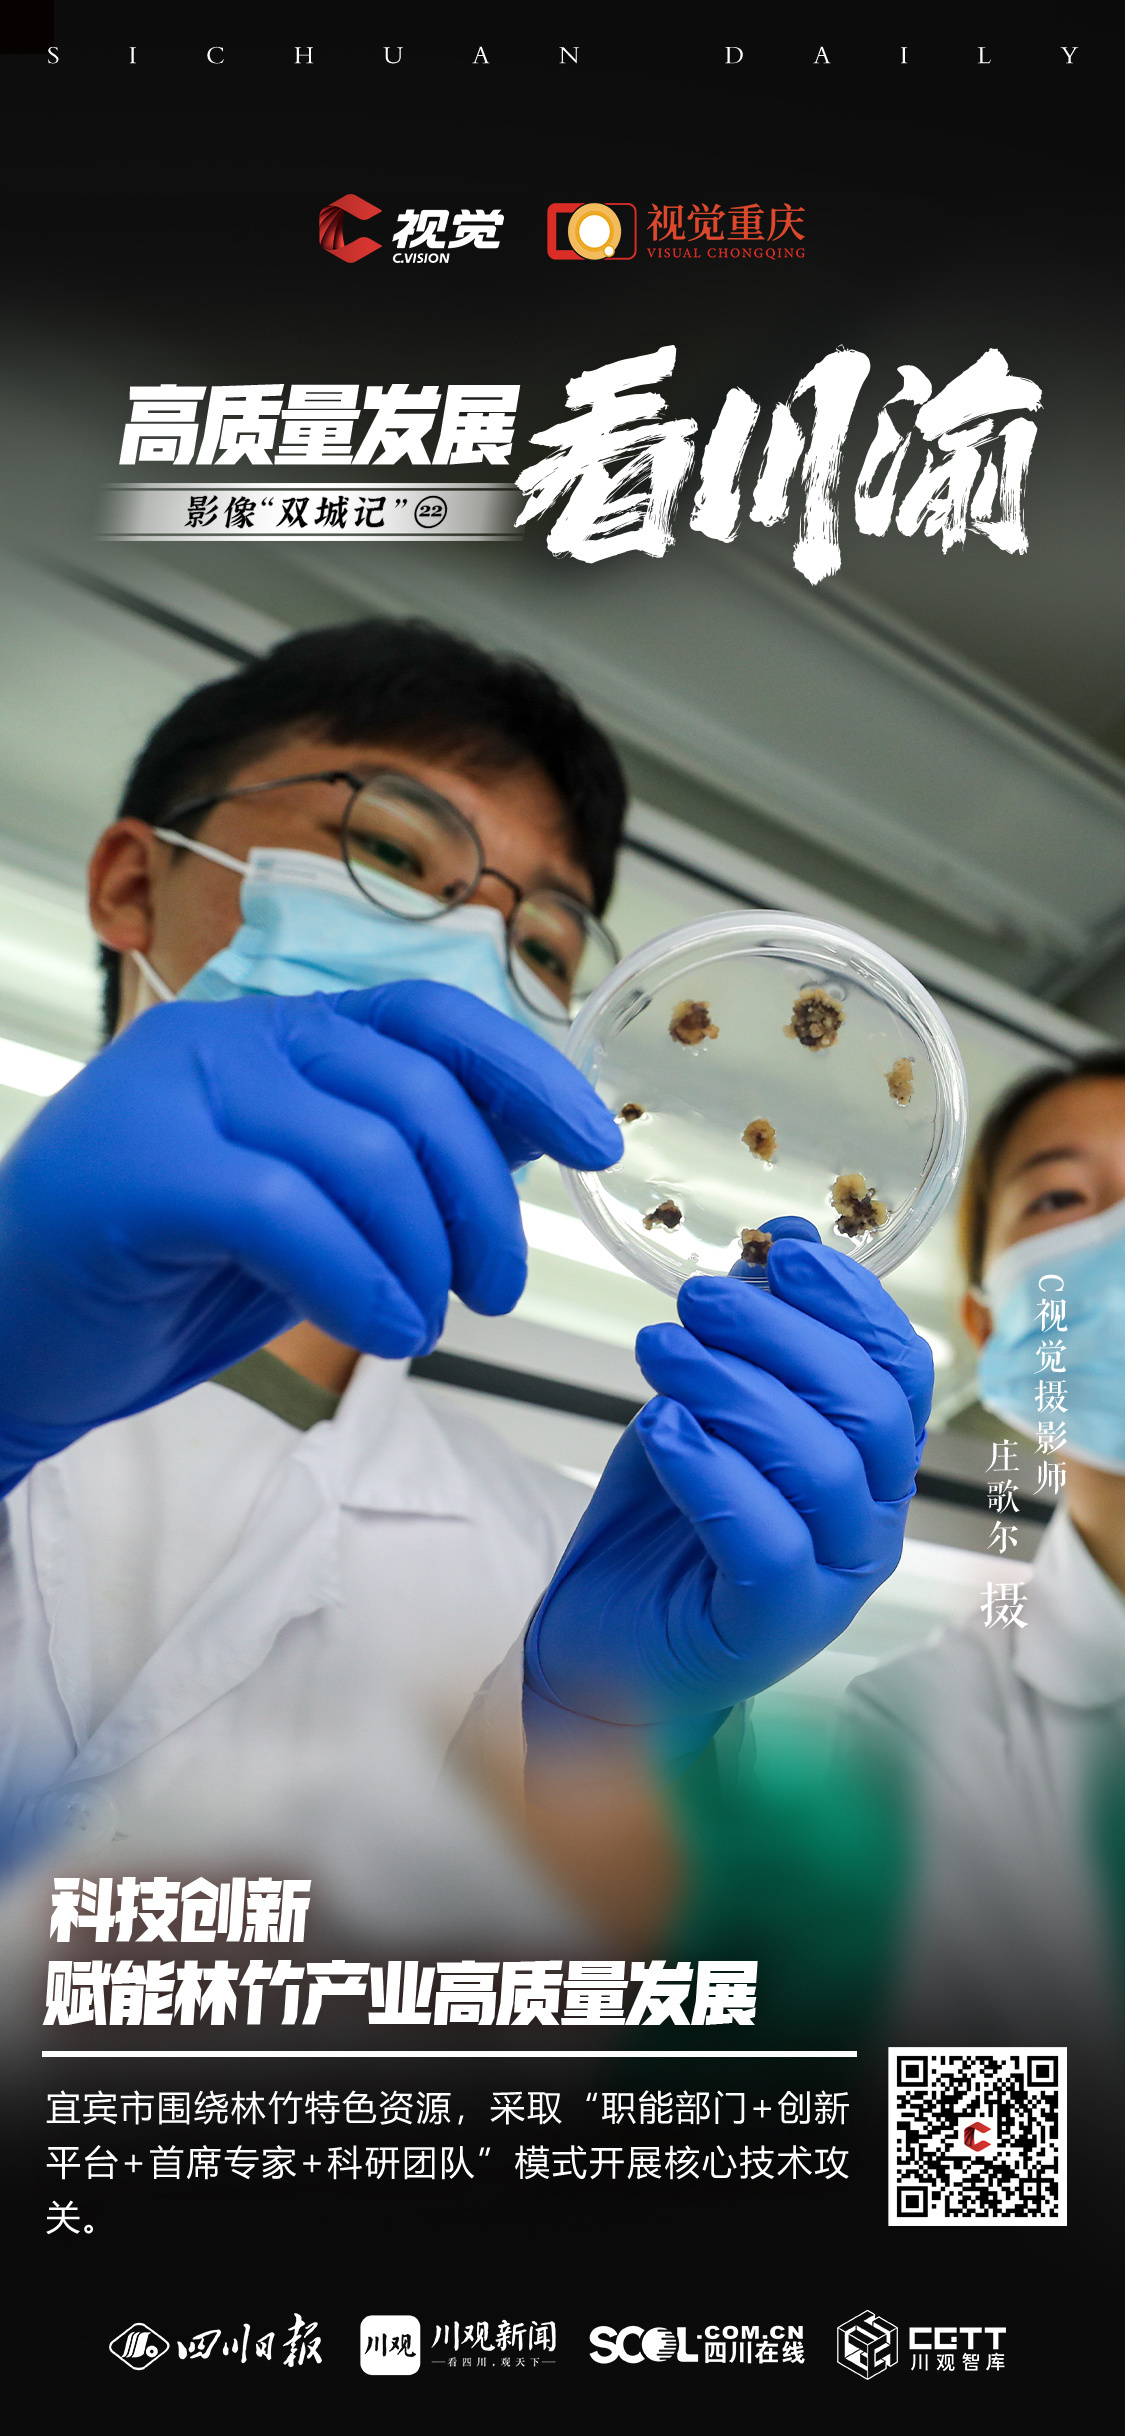

影像“双城记”
栏目语
共唱影像“双城记”,携手共建“经济圈”。
四川日报报业集团“C视觉影像数据库”与重庆日报报业集团“视觉重庆”联合启动“成渝地区双城经济圈影像共创计划”,推出《影像“双城记”》栏目。阅览成渝地区双城经济圈建设成就新篇章,绘就协同发展新蓝图。












C视觉 & 视觉重庆
联合出品
策划:毛漫丁 喻茂 谭曦
执行:赵增兴 郭佳莹
海报设计:何涛
C视觉摄影师:黄潇 庄歌尔 王宇
视觉重庆摄影师:孙凯芳 张坤琨 陈星宇 王加喜
【未经授权,严禁转载!联系电话028-86968276】
扫码查看
川观新闻 | 记者 赵增兴 何涛(视觉) 黄潇
2023-10-25 17:52
全文播报

视觉
进入频道
影像“双城记”
栏目语
共唱影像“双城记”,携手共建“经济圈”。
四川日报报业集团“C视觉影像数据库”与重庆日报报业集团“视觉重庆”联合启动“成渝地区双城经济圈影像共创计划”,推出《影像“双城记”》栏目。阅览成渝地区双城经济圈建设成就新篇章,绘就协同发展新蓝图。

C视觉 & 视觉重庆
联合出品
策划:毛漫丁 喻茂 谭曦
执行:赵增兴 郭佳莹
海报设计:何涛
C视觉摄影师:黄潇 庄歌尔 王宇
视觉重庆摄影师:孙凯芳 张坤琨 陈星宇 王加喜
【未经授权,严禁转载!联系电话028-86968276】

高质量发展
同舟共济扬帆起,乘风破浪万里航!